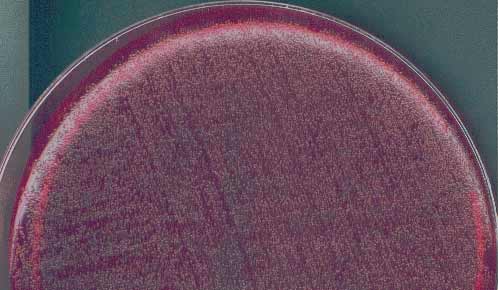

- Voici les aspects morphologiques des cultures obtenues sur la gélose au sang frais après 48 heures d'incubation à 37°C sous 5% de CO2 en aérobiose (en haut) et en anaérobiose (en bas):

- Le prélèvement a été aussi ensemencé sur une gélose GAR (gélose trypcase soja 5%) incubée à 37 °C sous 5 % de CO2 pendant 48 heures.

- Voici l' aspect de la culture obtenue sur la gélose GAR (gélose trypcase soja 5%) après 72 heures d'incubation à 37°C sous 5% de CO2:

Voici un autre aspect de culture:

- Parmi les tests d'orientation rapide est effectuée la recherche de l'hippurate dont voici les aspects au temps 0 (à droite) et après 2 heures de contact (à gauche):


- Certains caractères d'identification de ce germe aisément suspecté peuvent être recherchés à l'aide d'une galerie d'identification biochimique API, laquelle ?
A - API STAPH
B - API Rapid 32 ID
C - API CORYNE
D - API 20E
E - API 20NE
|
|
|
|
|